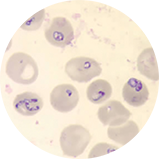
image of a blood smear showing Babesia parasites in red blood cells

Babesiosis
- Home
- Tick ID
- Overview of Tickborne Diseases
- Lyme Disease
- Tickborne Relapsing Fever (TBRF)
- Hard Tick Relapsing Fever
- Anaplasmosis
- Ehrlichiosis
- Rocky Mountain Spotted Fever
- Rickettsia parkeri Rickettsiosis
- Tularemia
- Babesiosis
- Heartland and Bourbon Virus Diseases
- Colorado Tick Fever
- Powassan Virus Disease
- Tickborne Diseases Abroad
- Tick Bites/Prevention
- Lyme Disease Prophylaxis After Tick Bite
Agent
Babesia microti and other Babesia species
Babesiosis is a disease caused by parasites that infect red blood cells. Most U.S. cases are caused by B. microti, which is transmitted mainly by Ixodes scapularis ticks, primarily in the Northeast and Upper Midwest and sporadically on the West Coast. Babesia parasites can also be transmitted via blood transfusion, perinatally, and via organ transplantation, anywhere, at any time of year. In 2019, the FDA licensed tests for the detection of Babesia species to utilize for screening of donors and recommended year-round regional testing for blood donations in areas endemic for babesiosis. Babesia infection can range from asymptomatic to life-threatening. Risk factors for severe babesiosis include asplenia, advanced age (age >50), and impaired immune function.
Babesiosis is most frequently reported from the Northeastern and Upper Midwestern United States in areas where microti is endemic; cases peak during spring and summer months. Sporadic cases of infection caused by novel Babesia agents have been detected in other U.S. regions, including the West Coast. Cases of babesiosis linked to B. divergens-like organisms have occurred in the Midwest region, Arkansas, Kentucky, Pennsylvania and Washington State. Cases linked to B. duncani have occurred on the West Coast of the United States. Transfusion-associated cases of babesiosis can occur anywhere in the country, at any time of year.
1-4 weeks following tick bite; 1-9 weeks after contaminated blood transfusion (up to 24 weeks)
Not all infected persons are symptomatic or febrile (an estimated 25% of infected adults and 50% of children are asymptomatic). The clinical manifestations, if any, usually develop within several weeks after exposure, but may develop or recur months later (for example, in the context of surgical splenectomy).
- Fever, chills, sweats
- Malaise, fatigue
- Myalgia, arthralgia, headache
- Gastrointestinal symptoms, such as anorexia and nausea (less common: abdominal pain, vomiting)
- Dark urine
- Less common: dry cough, sore throat, photophobia, conjunctival injection
- Mild splenomegaly, mild hepatomegaly, or jaundice may occur in some patients
- Severe cases can be associated with marked thrombocytopenia, disseminated intravascular coagulation, hemodynamic instability, acute respiratory distress, renal failure, hepatic compromise, altered mental status, and death.
Findings consistent with hemolysis include:
- Hemolytic anemia with decreased haptoglobin, elevated lactate dehydrogenase (LDH) values, and reticulocytosis
- Thrombocytopenia
- Elevated creatinine and blood urea nitrogen (BUN) values
- Mildly elevated hepatic transaminase values
- Proteinuria
- Identification of intraerythrocytic Babesia parasites by light-microscopic examination of a peripheral blood smear; or
- Positive Babesia (or B. microti) polymerase chain reaction (PCR) analysis; or
- Demonstration of a Babesia-specific antibody titer by indirect fluorescent antibody (IFA) testing for total immunoglobulin (Ig) or IgG
NOTE: If the diagnosis of babesiosis is being considered, manual (nonautomated) review of blood smears should be requested explicitly. In symptomatic patients with acute infection, Babesia parasites typically can be detected by blood-smear examination by experienced technicians, although multiple smears may need to be examined. It can be difficult to distinguish between Babesia and malaria parasites and even between parasites and artifacts (such as stain or platelet debris). Consider having a reference laboratory confirm the diagnosis, and if applicable, perform serologic or molecular testing to get a species-level identification.
NOTE: Antibody detection by serologic testing can provide supportive evidence for the diagnosis but does not reliably distinguish between active and prior infection.
Treatment decisions and regimens should consider the patient’s age, clinical status, immunocompetence, splenic function, comorbidities, pregnancy status, other medications, and allergies. Expert consultation is recommended for persons who have or are at risk for severe or relapsing infection or who are at either extreme of age (e.g., >50 years of age or neonates).
The typical regimens for adults are provided in the table below. Note that some patients diagnosed with babesiosis may have concurrent Lyme disease, or anaplasmosis or may be infected with other pathogens transmitted by Ixodes scapularisin a region. For pediatric dosing and non- microti treatment recommendations please reference the Clinical Practice Guidelines by the Infectious Diseases Society of America (IDSA): 2020 Guideline on Diagnosis and Management of Babesiosis.
| AGE CATEGORY | DRUG | PATIENT CATEGORY | DOSAGE | DURATION (DAYS)* |
|---|---|---|---|---|
| Adults*** | (Preferred Regimen)
Azithromycin + Atovaquone (with a fatty meal) Prescribe together |
Non-hospitalized
(mild to moderate disease) |
Azithromycin 500 mg orally on day 1; on subsequent days, give 250 mg every 24 hours | 7–10 |
| Atovaquone 750 mg orally every 12 hours | ||||
| Hospitalized
(acute severe disease) |
Azithromycin 500 mg IV every 24 hours until symptoms lessen, then transition to all oral step-down therapy | 7–10 | ||
| Atovaquone 750 mg orally every 12 hours | ||||
| Hospitalized
(step-down therapy) |
Azithromycin 250-500 mg** orally every 24 hours | 7–10 | ||
| Atovaquone 750 mg orally every 12 hours | ||||
| (Alternative Regimen)****
Clindamycin + Quinine Prescribe together |
Non-hospitalized
(mild to moderate disease) |
Clindamycin 600 mg orally every 8 hours | 7-10 | |
| Quinine 650 mg orally every 8 hours | ||||
| Hospitalized
(acute severe disease) |
Clindamycin 600 mg IV every 6 hours until symptoms lessen, then transition to oral step-down therapy | 7-10 | ||
| Quinine 650 mg orally every 8 hours | ||||
| Hospitalized
(step-down therapy)
|
Clindamycin 600 mg orally every 8 hours | 7-10 | ||
| Quinine 650 mg orally every 8 hours |
* The duration of therapy may be greater than 10 days for patients that are immunocompromised; highly immunocompromised patients may benefit from 6+ weeks.
** In immunocompromised adults, consider azithromycin doses of 500-1000 mg daily.
*** Patients with high-grade parasitemia (>10%), severe hemolytic anemia, or severe pulmonary, renal, or hepatic compromise may benefit from exchange transfusion. Expert consultation is strongly advised.
****Patients who fail to improve while on therapy with the preferred regimen or who are unable to take the preferred regimen should be treated with clindamycin and quinine.
NOTE: Most persons without clinical manifestations of infection do not require treatment unless parasites are seen on thin blood smear for >30 days.
Centers for Disease Control and Prevention. Babesiosis surveillance—18 states, 2011. MMWR 2012;61: 505–9.
Diuk-Wasser MA, Vannier E, Krause PJ. Coinfection by Ixodes tick-borne pathogens: Ecological, epidemiological, and clinical consequences. Trends Parasitol. 2016;32(1):30-42.
Herwaldt BL, Linden JV, Bosserman E, et al. Transfusion-associated babesiosis in the United States: a description of cases. Ann Intern Med. 2011;115:509–19.
Glanternik JR, Baine IL, Rychalsky MR, et al. A cluster of cases of Babesia microti among neonates traced to a single unit of donor blood. Pediatr Infect Dis J. 2018 Mar;37(3):269-271.
Krause PJ, Auwaerter PG, Bannuru RR, et al. Clinical practice guidelines by the Infectious Diseases Society of America (IDSA): 2020 guideline on diagnosis and management of babesiosis. Clin Infect Dis. 2021 Jan 27;72(2):e49-e64
Krause PJ. Human babesiosis. Int J Parasitol. 2019 Feb;49(2):165-174.
Kumar A, O’Bryan J, Krause PJ. The global emergence of human babesiosis. Pathogens. 2021;10(11):1447.
Kumar P, Marshall B, deBlois G, et al. A cluster of transfusion-associated babesiosis in extremely low birthweight premature infants. J Perinatol. 2012;32, 731–733.
Moniuszko A, Dunaj J, Swięcicka I, et al. Co-infections with Borrelia species, Anaplasma phagocytophilum and Babesia spp. in patients with tick-borne encephalitis. Eur J Clin Microbiol Infect Dis. 2014 Oct;33(10):1835-41.
Steiner FE, Pinger RR, Vann CN, et al. Infection and co-infection rates of Anaplasma phagocytophilum variants, Babesia spp., Borrelia burgdorferi, and the rickettsial endosymbiont in Ixodes scapularis (Acari: Ixodidae) from sites in Indiana, Maine, Pennsylvania, and Wisconsin. J Med Entomol. 2008 Mar;45(2):289-97.
US Food and Drug Administration. Guidance for industry: recommendations for reducing the risk of transfusion-transmitted babesiosis. Silver Spring, MD: CBER: Office of Communication OCOD; 2019.
Vannier E, Krause PJ. Human babesiosis. N Engl J Med. 2012;366:2397–407.
Vannier EG, Diuk-Wasser MA, Ben Mamoun C, et al. Babesiosis. Infect Dis Clin North Am. 015;29(2):357-370.
Wormser GP, Dattwyler RJ, Shapiro ED, et al. The clinical assessment, treatment, and prevention of Lyme disease, human granulocytic anaplasmosis, and babesiosis: clinical practice guidelines by the Infectious Diseases Society of America. Clin Infect Dis. 2006;43:1089–134. Erratum in: Clin Infect Dis. 2007;45:941.
Wormser GP, Prasad A, Neuhaus E, et al. Emergence of resistance to azithromycin-atovaquone in immunocompromised patients with Babesia microti infection. Clin Infect Dis. 2010;50:381–6.